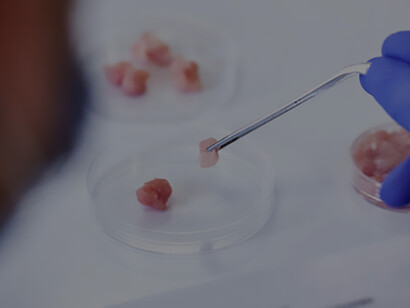
Cultivated meat sample being held with a set of tweezers

Inescapably, meat production is a significant contributor to greenhouse gas emissions, which are fueling climate change. That’s because mass animal farming to support our meat-eating habit generates considerable quantities of greenhouse gases, which are heating up the planet.
It is almost impossible to overstate the environmental impact of the meat industry. Research has found that over a third of global greenhouse gas emissions can be explained by meat production processes. That means meat production contributes more to climate change than the entire American economy.1
That’s why there is a growing movement for a plant-based diet. Around the world, millions of people are giving up meat and animal products. That often means switching to vegan meat substitutes. But that decision brings with it its own set of problems, especially when those products are made of soy.
Unfortunately, while it is well-intentioned, a lot of the plant-based movement risks oversimplifying the issues. Avoiding meat might well dodge the greenhouse gas emissions of the meat industry, but it does often come with its own downsides. Ensuring an environmentally sustainable diet is a complex and nuanced endeavor.
The production of soy-based meat substitute products poses significant environmental challenges. Soy growth leads to soil erosion, water depletion, and deforestation on a mass scale, which also means it has a substantial effect on biodiversity and the health of natural ecosystems. Shifting from meat to soy-based products is not necessarily a win for the environment.2
That’s where cultured meat comes in. Otherwise known as lab-grown meat, it is a revolutionary technology which promises to transform the food industry from top to bottom. By cultivating meat in a laboratory setting and therefore foregoing the need for animal farming, cultured meat helps address both the environmental and ethical concerns associated with conventional meat production.3
The biggest advantage of lab-grown meat is that its greenhouse gas emissions are minimal. Traditional animal farming results in a very high level of methane emissions, especially when farming cows, which is a major contributor to climate change. That is a non-issue with lab-grown meat, which offers a more sustainable way forward.
The development of lab-grown meat technologies has seen rapid progression in recent years. For instance, one company has gained regulatory approval to sell their products in mainstream markets.4 Predictions and analysis of the fast-growing industry suggest lab-grown meat could comprise up to a quarter of global meat consumption by 2035, signaling a significant shift in dietary habits towards more sustainable options.5
Another significant advantage of cultured meat is that it preserves consumer choice. The simple fact is that people like eating meat. All over the world, entire cuisines are predicated on the availability of a wide range of meat products. While some enjoy the vegan lifestyle, it is not for everyone.
By growing meat in a lab, we allow people to retain access to a wide variety of protein products as they have now, but in a more environmentally sustainable way. That means you can continue eating steak or chicken while saving the planet. No longer do we have to make big sacrifices in our diets and resist the desire to buy and eat meat in order to help slow down climate change.
Embracing cultured meat represents a pragmatic approach to mitigating the environmental impact of meat consumption while also preserving consumer choice. Rather than sacrificing taste, variety, or nutritional quality, consumers can continue to enjoy meat products without feeling that they are undermining environmental sustainability in the process.
This innovative solution marks a departure from the limitations of traditional dietary approaches, which force consumers to choose between eating meat from animals or not. Instead, thanks to innovation and progress in this industry, we now have a pathway to a more sustainable future.
To put it simply, the future of meat lies in innovation, not abstention. At the moment, it looks like cultured meat is the way forward. This technology presents a viable and environmentally friendly alternative to conventional meat production, paving the way towards a more sustainable food production system. By embracing innovation and supporting the development of cultured meat, we can protect the planet while continuing to enjoy the foods we love.
References
1 Meat accounts for nearly 60% of all greenhouse gases from food production, study finds.
2 Is Soy Bad for the Environment?
3 Welfare issues for dairy cows.
4 Lab-Grown Meat Approved for Sale: What You Need to Know.
5 How well is Europe playing the cultured meat game? What the numbers tell us.